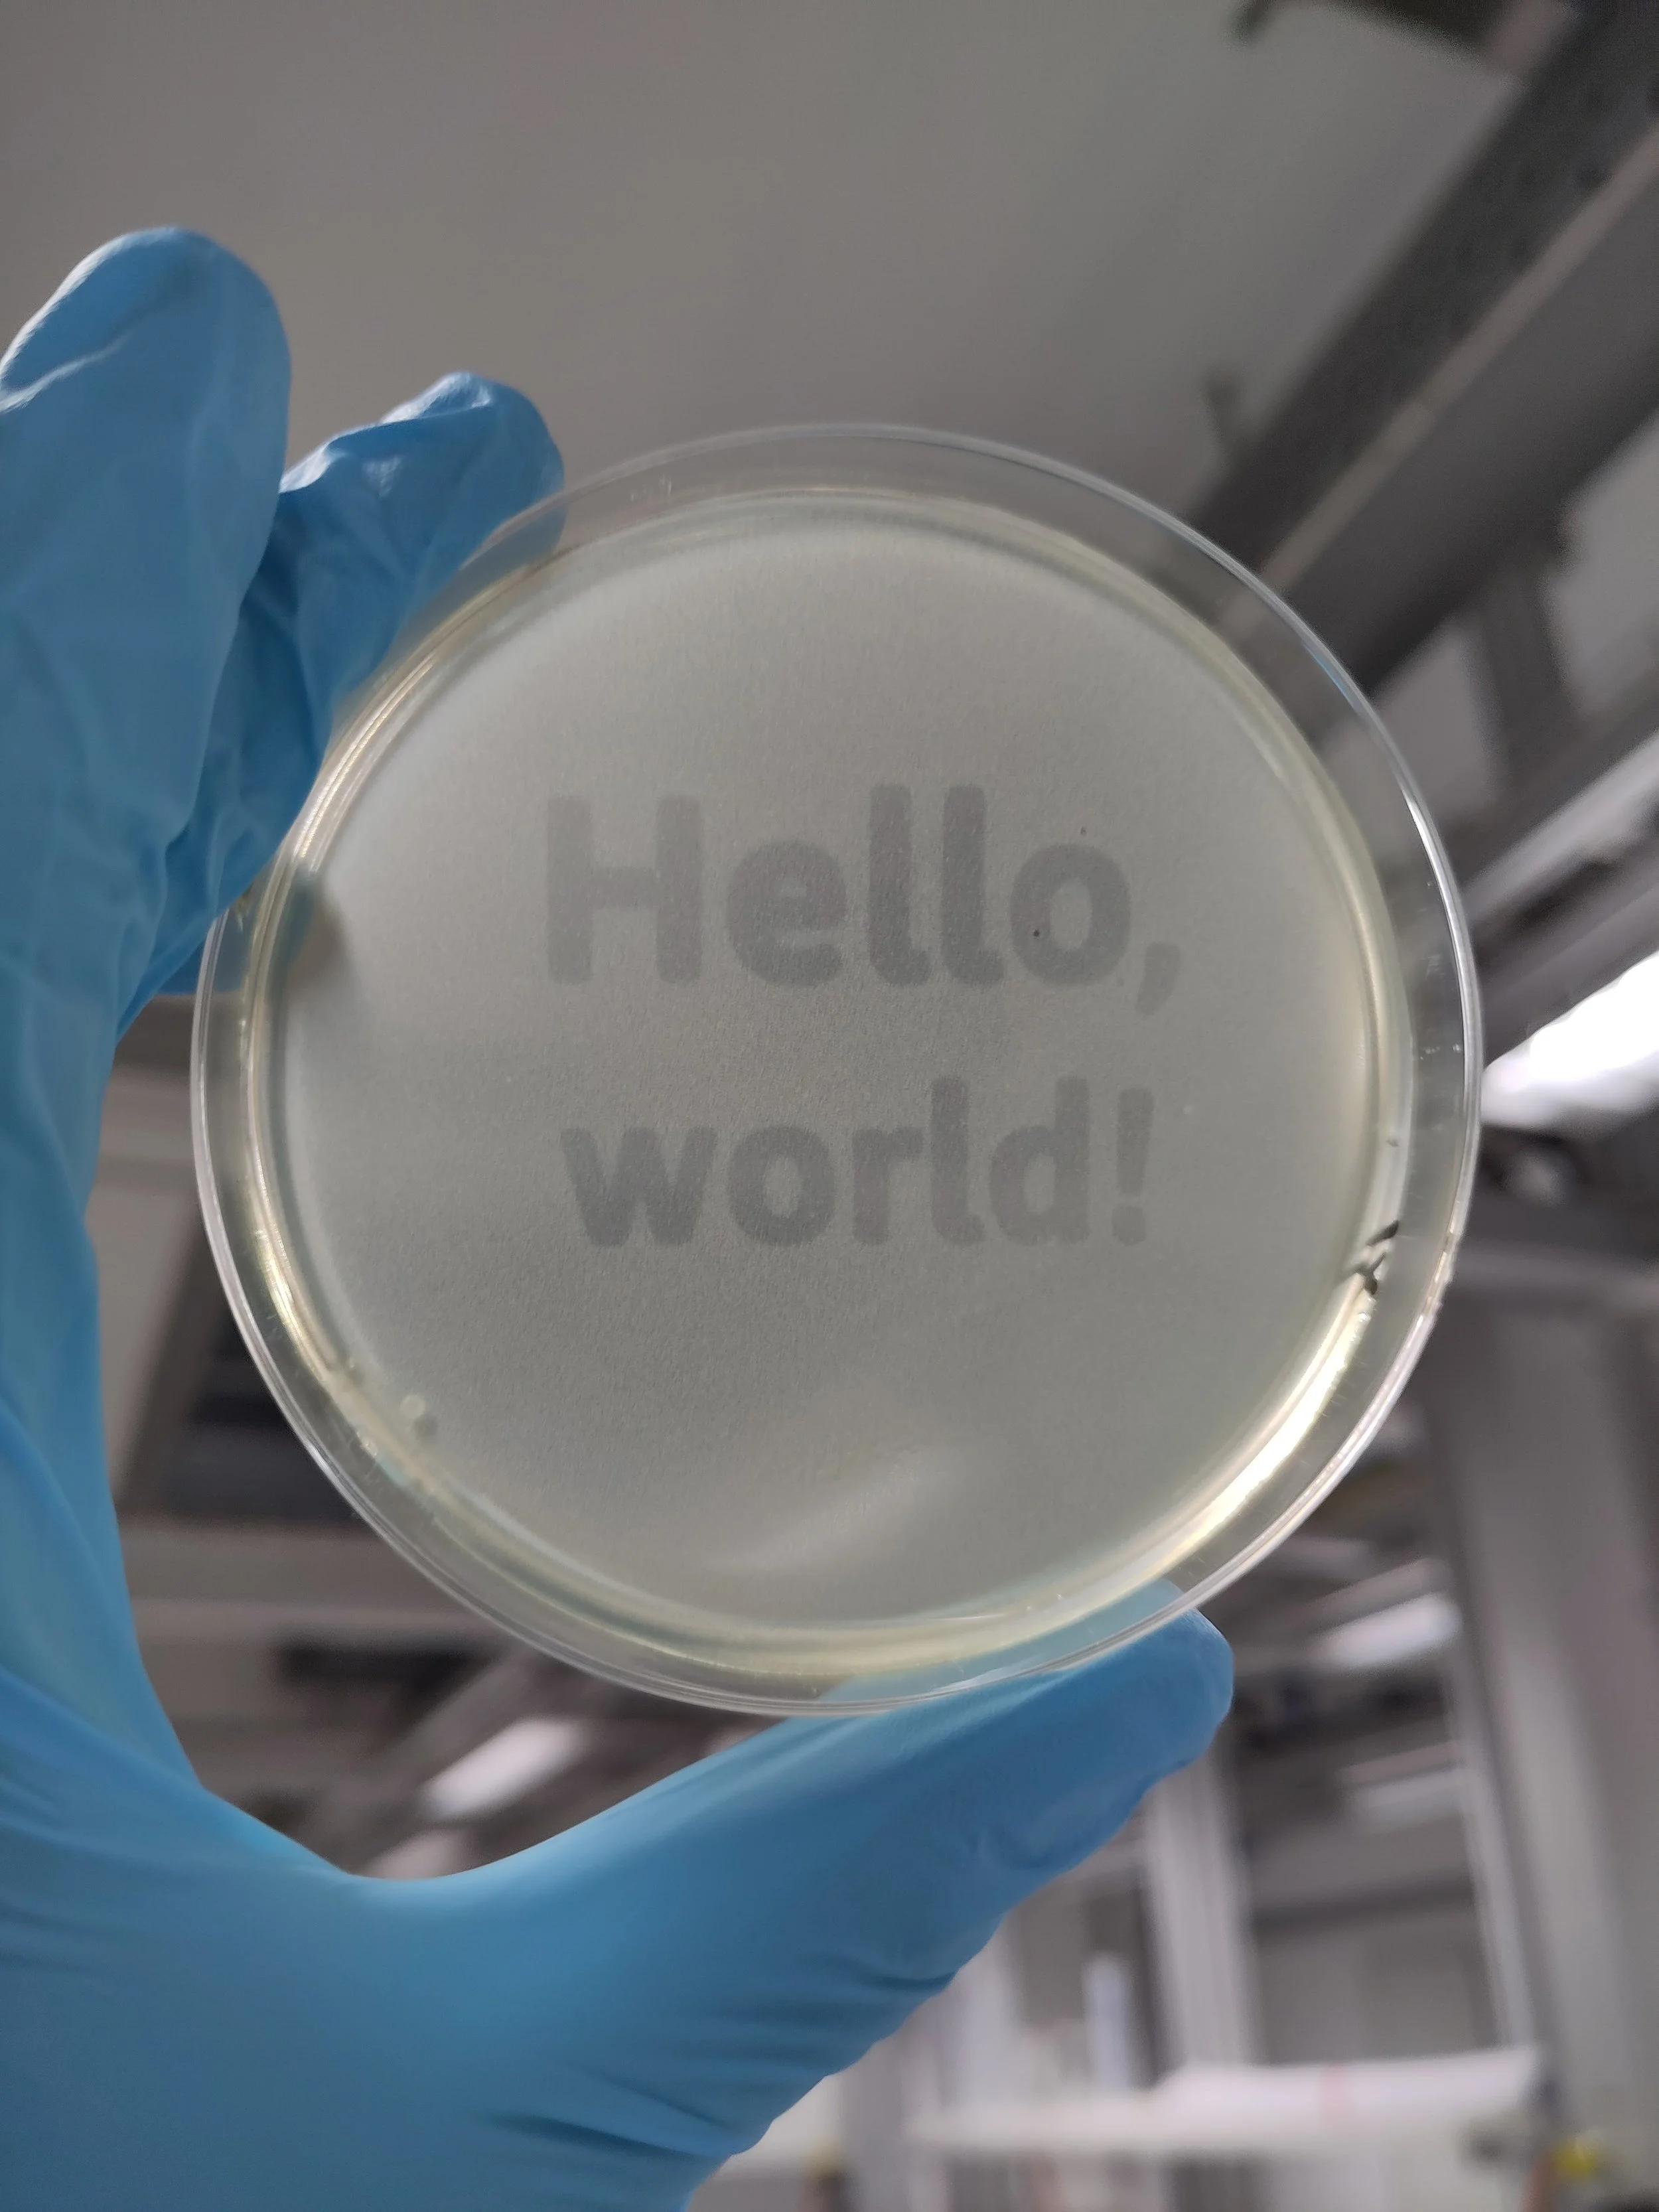

Inspiring Switzerland’s next generation of Bio Entrepreneurs
The Student Biolab is a platform and a community for students to design, prototype, and implement their life science research and product ideas. Based at UZH Irchel and ETH Hönggerberg it engages students from UZH and ETH.

We aim to provide:
Lab space with equipment & reagents
Financial support for student projects
A community in the Biology space
Expert guidance & advice
Upcoming Events
*
Upcoming Events *
Next event:
🔬 Welcome Event HS25 – Wed., October 1st 🔬
Start the new semester in style and join us at the Welcome Event on Wednesday, October 1st, starting at 6.30 PM!
When: Wednesday, 1st of October, 6.30 PM
Where: Student Project House (Zentrum), E-Floor (Clausiusstrasse 16, 8006 Zürich)
Free food & drinks
Discover everything about this year’s competition teams & their projects:
🌍 TERRA – how iGEM ETH is turning waste into an opportunity.
🧪 TRACE – the new fast, easy, and reliable STI test being developed by iGEM UZurich.
🧬 Evolution Suisse – how the iDEC team is evolving RNA-guided DNA recombinases.
🔬 BioIncubate – the way of transforming biotech ideas into impactful solutions.
🫂 Community – all the ways to have fun with Student Biolab!
The evening will feature Sasha Melkonyan, scientific co-founder of Nerai Bioscience, a biotechnology company that focuses on revolutionizing genetic medicine.
Explore Student Biolab, our mission, and exciting projects. Connect with like-minded individuals and kickstart the semester with innovative research and collaborations! 🍻